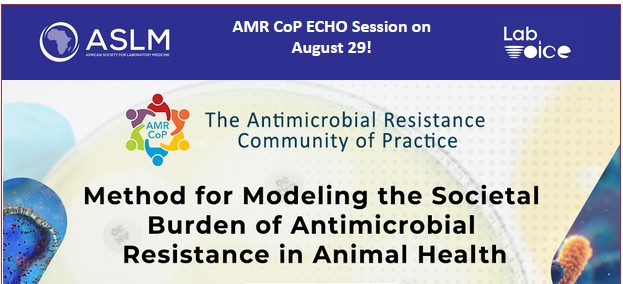

June 04 2026 LabCoP Extended ECHO Session: Data-driven strategic planning and prioritization: Lessons from Nigeria’s National Tuberculosis, Leprosy, and Buruli Ulcer Control Program
Programmatic planning and prioritization should be data-driven, inclusive, and aligned with broader health system goals. However, weaknesses in routine data systems, including limi
May 28 2026 LabCoP Extended ECHO Session: Moving from a Pilot project and siloed interventions to a system-based approach for improved health: A Global Call
Integrated diagnostics is an essential strategy for delivering cost-effective, people-centered health services. Tuberculosis services present an entry point for integration through
August 2025 AMR CoP ECHO Session: Antimicrobial Stewardship: Practical Insights for Resource-Limited Settings
22 August 2025 This webinar, titled “Antimicrobial Stewardship: Practical Insights for Resource-Limited Settings,” explores how antimicrobial stewardship (AMS)—when imp
August 2025 AMR CoP ECHO Session: Modelling Societal Burden of AMU/AMR: Introducing Productivity Adjusted Life Years (PALYs)
29 August 2025 This webinar, titled “Modelling Societal Burden of AMU/AMR: Introducing Productivity Adjusted Life Years (PALYs),” expands on the “burden of dise
September 2025 AMR CoP ECHO session: Antimicrobial Resistance Surveillance Landscape Analysis Toolkit
26 September 2025 This session focuses on the AMR Surveillance Landscape Analysis Toolkit—a structured package of tools designed to help countries independently assess and streng
September 2025 LabCoP Extended ECHO Session: From Policy to Practice: The Operational Realities of the South African TB diagnostic multiplatform approach
25th September 2025 TB diagnostic programs have historically relied on a single technology model. However, in high-volume settings, low-complexity molecular platforms alone may not
June 2025 LabCoP Extended ECHO session: Making Genomics Work for TB: Practical and Cost-Effective Use of tNGS in TB Programs
The emergence of drug-resistant TB remains a global health threat, with only one-third of individuals estimated to have multi-drug (MDR) or rifampicin-resistant (RR) TB diagnosed a
May 2025 LabCoP Extended Echo Session. Closing the gap in drug-resistant TB diagnosis: the critical role of sequencing
The emergence of drug-resistant TB remains a global health threat, with only one-third of individuals estimated to have multi-drug (MDR) or rifampicin-resistant (RR) TB diagnosed a
May 2025 LabCoP Extended ECHO Session: Experiences, challenges and lessons learnt in improving the public health laboratories surveillance capabilities for priority diseases The experiences of Burkina Faso, and São Tomé and Príncipe
In this ECHO session,São Tomé and Príncipe, and Burkina Faso shares their experiences, challenges, lessons learnt and priority areas in improving detection, surveillance and res